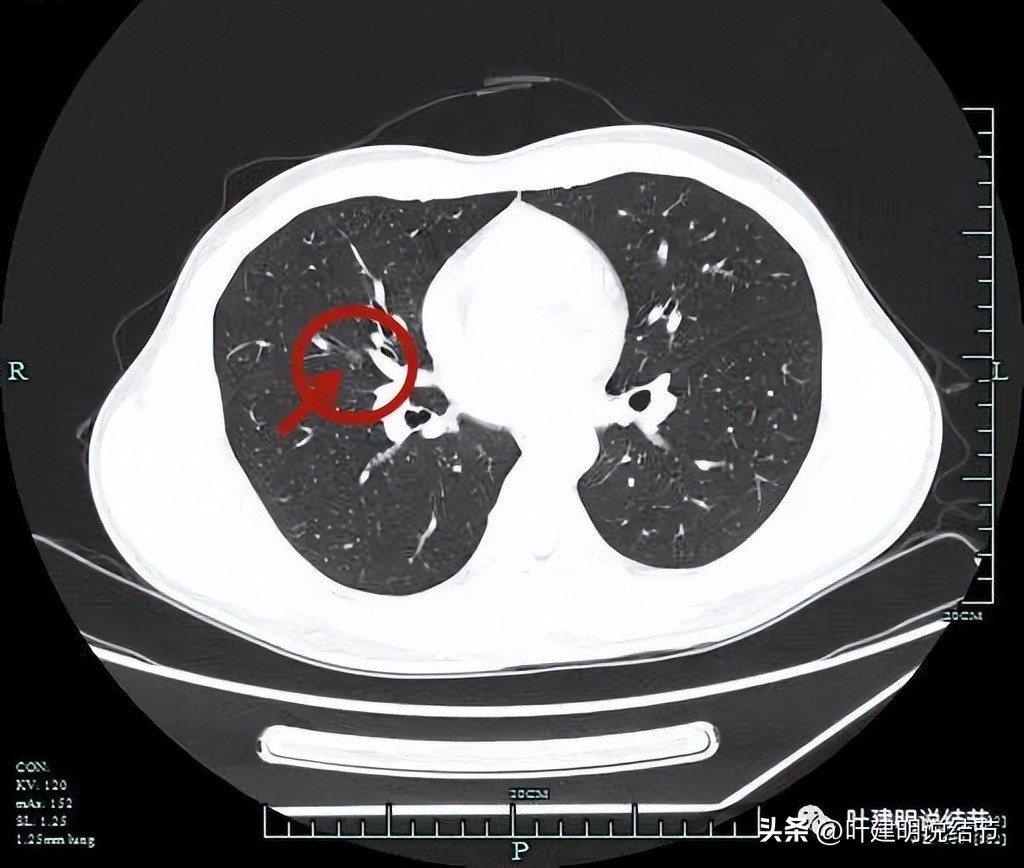
中叶多发微小结节,男性30岁右侧甲状腺单发结节
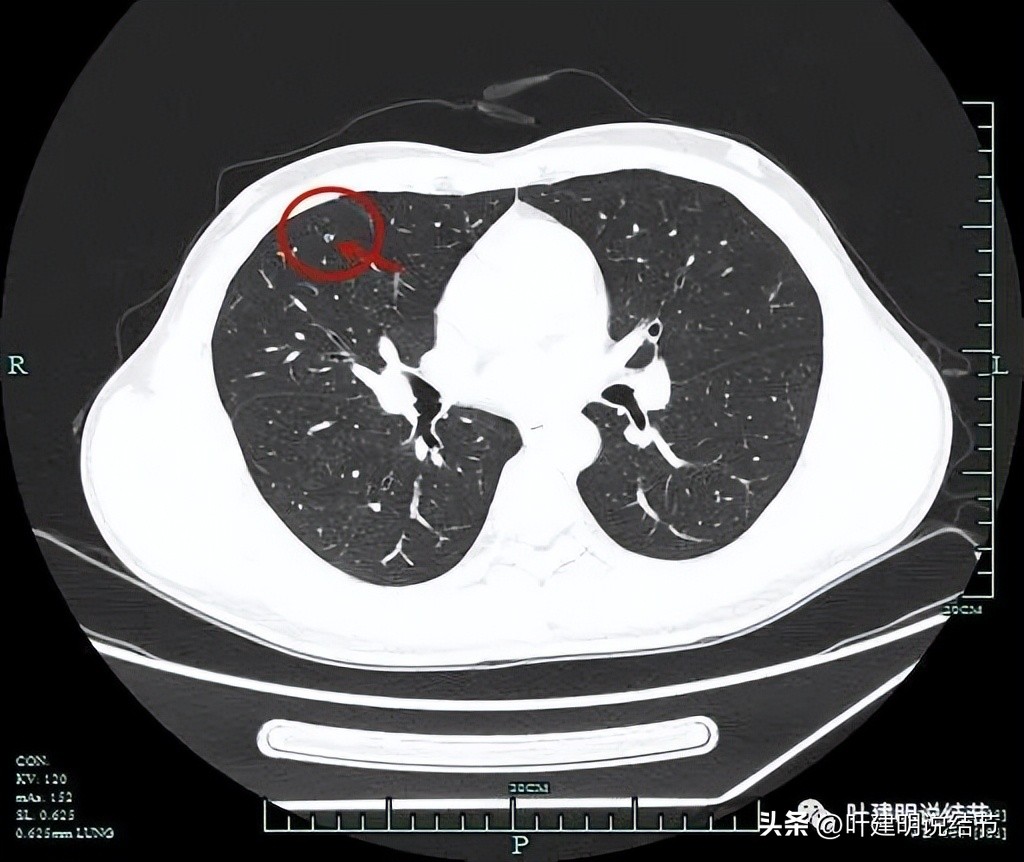
中叶多发微小结节,男性30岁右侧甲状腺单发结节

手术病例分享:
(文中含手术标本展示,请注意选择点击阅读)


杭州的某A,今年才29岁,近半年经常有咳嗽症状,但没有谈,咳的也不剧烈。当地查了胸部CT后提示肺磨玻璃结节影,给予了抗生素治疗,也没什么改善。因为有亲戚在浙江大学医学院附属杭州市肿瘤医院工作,遂来到我们医院就诊,给查了胸部CT平扫以及靶扫描后同事找到我看片子,虽然考虑是恶性,但还要不要要随访,还是可以选择手术了?我们来瞧瞧他的影像:
薄层平扫见三处病灶:

病灶1:右中叶磨玻璃结节,瘤肺边界与轮廓非常清楚,一看就是肿瘤范畴的结节,只是实性成分不明显,危险性可能还不算大。
病灶2:右中叶靠近肺门部,外侧段支气管壁紧邻处磨玻璃结节,感觉轮廓也较清,边缘不太光滑,考虑恶性范畴的可能性大些。

病灶3:右中叶内侧段胸膜下微小实性结节伴空泡征,密度过小,病灶过小,考虑良性结节。
再来看靶扫描影像:
病灶1:







病灶2:




病灶3的薄层:

影像印象:
右肺中叶多发结节,主病灶与次病灶均为磨玻璃密度,主病灶瘤肺边界清,轮廓也很清,并有血管进入,总体实性成分不明显,但因明显的血管征,考虑应该至少微浸润性腺癌可能性大,也不能完全除外浸润性腺癌的贴壁型,可以考虑手术治疗;次病灶位于近肺门部,也是磨玻璃结节,而且边不光整,密度也显各不均匀,怀疑原位癌或微浸润性腺癌可能性大。虽然目前小而没有实性成分,但如果主病灶要干预,此灶也得一并切除;病灶三由于非常微小,而且密度甚高,虽有空泡征,仍考虑是良性的可能性大得多(空泡征或空腔征在实性结节中不适用作为恶性特征表现之一)。
临床决策:
目前病灶三几乎没有风险,病灶一有浸润性腺癌的可能,且明显异常血管进入,紧贴胸膜,存在一定风险;病灶二较小,虽也恶性,近期风险似乎应该不大,可它与段支气管关系密切,如果有浸润性,容易侵犯支气管,还是有一定危险的。所以我是建议不必要再随访观察,还是手术干预为宜。如果只有病灶一,也可只行楔形切除,淋巴结可采也可不采,因为纯磨不管什么病理类型,都不至于说有转移;但由于病灶二存在,不能只切主病灶,而留下次病灶,所以可以考虑中叶切除,这样顺利也切了病灶三,虽然它良性可能性大,但也是有病理依据更加放心。由于均没有明显实性成分,所以经过与患方充分沟通后,拟行单孔胸腔镜右中叶切除加淋巴结采样(主要是第11组以及第12组)。肺门与纵隔淋巴结不予以清扫,减少无谓的创伤,减少术后淋巴液渗出和刺激性咳嗽的症状。
最后结果:
手术如期按既定计划进行,过程顺利。胸内操作时间仅半个多小时。下面是大体标本的样子:

上图是主病灶剖面观

上图是主病灶表面观

上图是次病灶剖面观

上图是病灶3的样子
下面是病理切片结果:

这个病例好在多原发早期肺癌均在右中叶,中叶切除就解决了目的所有问题,而且主病灶病理已经是浸润性腺癌,好在仍是纯磨玻璃密度,切了就应该治愈。次病灶从影像上看,表现不光,也可能会是微浸润性腺癌,等常规病理再看看。不过不管最后常规病理是啥,术后均不需要辅助治疗。当然后续的定期复查还是必要的,不是因为怕转移或复发,而是及早发现并监测很可能会再新发的磨玻璃结节。

(此处已添加医疗卡片,请到*今条头日**客户端查看)